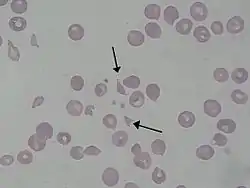

كرية منفلقة
كرية منفلقة[1] أو كرية تشققية[1] أو كرية فلقية[1] أو كريرة منفلقة[2] أو الفصيمة كروِية[3] تكون عبارة عن جزء من خلية دم حمراء.الفصيمة الكروية تكون غير منتظمة الشكل وغير متجانسة.الفصيمة الكروية الحقيقية لاتحتوي على شحوب في المنتتصف.
شريجة دم لشخص مصابة ب hemolytic-uremic syndrome
عدة امراض تصيب الاوعية الدقيقة، منها تخثر منتثر داخل الأوعية و thrombotic microangiopathies والتي تنتج الفبرين والذي يسبب تكسير خلايا الدم الحمراء عند المرور من هذه الكتلة والذي ينتج فصيلة كروية. الفصيلة الكروية تشاهد عادةً عند الأشخاص المصابيين بفقر الدم الانحلالي. وتكون أيضاً نتيجة صمام القلب الاصطناعي.
عندما تتواجد كمية كبيرة من الفصائم الكروية في الدم، هذه علامة على فَقْرُ الدَّمِ الآنْحِلالِيُّ النَّاجِمُ عَن اعْتِلالِ الشُّعَير والذي يكون أكثر سبب شائع هو ضيق في الشريان الأورطي.
المراجع
- قاموس مرعشي الطبي الكبير نسخة محفوظة 19 أغسطس 2017 على موقع واي باك مشين.
- القاموس الطبي نسخة محفوظة 19 أغسطس 2017 على موقع واي باك مشين.
- المعجم الموحد نسخة محفوظة 19 أغسطس 2017 على موقع واي باك مشين.
- بوابة طب
- بوابة علم الأحياء
في كومنز صور وملفات عن: كرية منفلقة
This article is issued from Wikipedia. The text is licensed under Creative Commons - Attribution - Sharealike. Additional terms may apply for the media files.